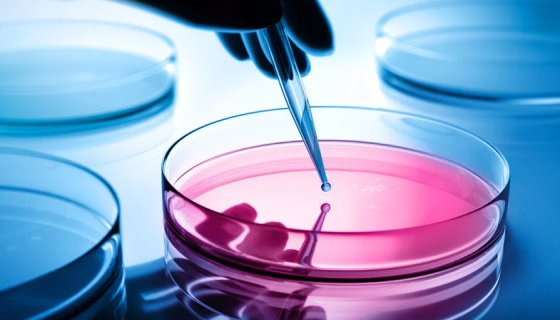
细胞培养基的构成与配制及储存与使用方法！

小鼠树突细胞DC2.4复苏与传代及冻存操作说明!
小鼠树突细胞DC2.4取自C57BL/6小鼠,仅用于科学研究...

BT-474人乳腺导管癌细胞的处理方法与培养步骤!
人乳腺导管癌细胞,仅用于科学研究或者工业应用等非医疗目的不可...

胶质芽孢杆菌的产品效能与主要作用及使用方法!
胶质芽孢杆菌是高薪技术研发的新型粉剂微生物菌种,活菌含量高,...

百日咳杆菌的生物学性状及微生物学诊断与防治原则!
百日咳杆菌(Bordetella pertussis)为卵圆...

人外周血单核细胞的性质与用途及生产工艺!
人外周血单核细胞分离自外周血;外周血是除骨髓之外的血液,临床...

MDA-MB-231人乳腺癌细胞的培养方式及注意事项!
人乳腺癌细胞的培养方式与质量检测及注意事项有哪些?
细胞培养基的构成与配制及储存与使用方法!
细胞培养基的种类繁多,细胞培养方式也较多,如何正确地使用培养...

PBMC小鼠外周血单核细胞的分离方法与质量检测!
小鼠外周血单核细胞分离自外周血;外周血是除骨髓之外的血液,临...

ATCC MYA-1043 火木层孔菌的形态特征与经济用途!
火木层孔菌,用于崩漏带下。活血,化饮,癖饮,和胃止泻,用于脾...